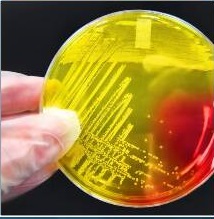

![]() quinoa | ![]() keresztmerevítés | ![]() hajlakk | ![]() grottó | ![]() metszéspont | ![]() száloptika |
![]() rögzítő | ![]() kasszava | ![]() vízum | ![]() előadás | ![]() dicsekvő | ![]() ragyog |
![]() szeizmogram | ![]() bordaszelet | ![]() minta | ![]() tengerfenék | ![]() omlett | ![]() kolombusz |
![]() devérkeszeg | ![]() lovashajtó | ![]() parkour | ![]() pirotechnika | ![]() rézsútos_metszés | ![]() galopp |
![]() színpad | ![]() ráspoly | ![]() okulár | ![]() filmnegatív | ![]() ekler_fánk | ![]() bergamott |
![]() shiatsu | ![]() tüzelőtároló | ![]() utász | ![]() presszókávé | ![]() pórusok | ![]() oázis |
![]() pakura | ![]() zsilip | ![]() bojtorján | ![]() ló_tornaszer | ![]() zsalugáterek | ![]() fennsík |
![]() féldombormű | ![]() balett_társulat | ![]() ostor | ![]() csere | ![]() fémkohászat | ![]() mozaik |
![]() ayurvéda | ![]() ipari_tanuló | ![]() stegosaurus | ![]() csille | ![]() tárló | ![]() csillagfürt |
![]() penna | ![]() gozinaki | ![]() kapocs | ![]() összeállítás | ![]() válság | ![]() maximum |
![]() timpanon | ![]() párhuzamos | ![]() agyaggolyó | ![]() fűző | ![]() olajoskanna | ![]() angolna |
![]() siklóhajó | ![]() mészkő | ![]() próba | ![]() citoplazma | ![]() pikkelyek__bőr_ | ![]() függőón |
![]() gyümölcsvelő | ![]() csillószőrök | ![]() filmszereplő | ![]() Tányérsapka | ![]() kasztanyetta | ![]() fatönk |
![]() földszoros | ![]() kolónia | ![]() ágyéki | ![]() _0_fok | ![]() lélek | ![]() zöldségágyás |
![]() mérgező | ![]() töredék | ![]() pénztáros | ![]() macaron | ![]() vacuola | ![]() öblít |
![]() kardinálispinty | ![]() ízléses | ![]() dunlop | ![]() foltozóvarga | ![]() lovasparádé | ![]() fúvóka |
![]() pilaszter | ![]() üveg | ![]() világítórák | ![]() ugródeszka | ![]() hullámvonal | ![]() gipszöntvény |
![]() botanika | ![]() zátony | ![]() reaktor | ![]() bizalom | ![]() őszül | ![]() polenta |
![]() kvarc | ![]() varrat | ![]() lóversenypálya | ![]() svájc | ![]() steampunk | ![]() zuzmó |
![]() fondü | ![]() nemezelés | ![]() járat | ![]() kötélrögzítő | ![]() fogaskerekű | ![]() manőver |
Látták: 5864
Nézik: 1
Megoldások: 1270 db
Nézik: 1
Megoldások: 1270 db